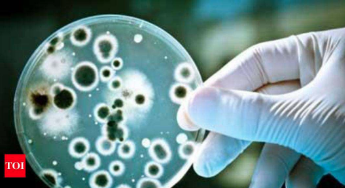

Nagpur: Indiscriminate use of antibiotics has led to a situation that the disease-causing organisms have become resistant to most of the antibiotics used to control them. The medical community fears that it will be left with no higher antibiotics to control acute infections in near future.
Nagpur: Indiscriminate use of antibiotics has led to a situation that the disease-causing organisms have become resistant to most of the antibiotics used to control them. The medical community fears that it will be left with no higher antibiotics to control acute infections in near future.Hence with the aim of minimizing this rampant and unscientific use of antibiotics, the Indian Critical Care Medicine Society (ICCMS) has prepared national guidelines on antibiotic use in intensive care units (ICUs) in hospitals as they are the places where most higher antibiotics are used. It is for the first time that such India centric guidelines have come up.
Dr KK Aggarwal, former national president of Indian Medical Association told TOI that a 40-member committee headed by Dr G C Khilnani from AIIMS New Delhi has prepared these guidelines. The guidelines have been put forth in front of Indian Council of Medical Research which will put it to the union health ministry for adopting. “There should be a uniform policy for use of antibiotics in hospital ICUs for two reasons mainly. It will prevent drug resistance and minimize the treatment cost. Above all it will minimize deaths,” Dr Aggarwal said.
The guidelines include the basic principles like when not to use antibiotics, when to start antibiotics, when to switch from intravenous administration to oral consumption, when to de-escalate the antibiotics or move to lower form of antibiotics, move from broad to narrow spectrum and from multiple drugs to single drug. Since every hospital has certain unique microorganisms in its premises, which cause hospital borne infections, the hospital is expected to prescribe antibiotics accordingly. Thus, each hospital must have its own policy as well on antibiotic prescription, said Dr Aggarwal.
Dr Deepak Jaiswani, former president of Society of Critical Care Medicine (SCCM), Nagpur, said that these guidelines were welcome as it is a move towards appropriate and rational use of antibiotics. He said all NABH accredited hospitals already are expected to follow certain regulations for use of antibiotics. The accrediting agency randomly inspects the hospitals, audits the antibiotics use and asks for justifying the antibiotic prescription.
Dr Nikhil Balankhe, present SCCM president too stresses that the guidelines will restrict the antibiotic use and bring an uniformity nationally in prescribing these medicines. “There is unindicated use of antibiotics. There are community acquired infections. If antibiotic use is not restricted, it will leave us with no antibiotics soon as most of them have become resistant. There is a antibiotics stewardship programme as well like the guidelines which will add to this effort.
Dr Nirmal Jaiswal, adviser to SCCM, says that with a set protocol, diseases will be treated better. He said antibiotics should not be used empirically. They should be used based on the culture sensitivity of organisms present in body fluids to prevent antibiotic resistance.